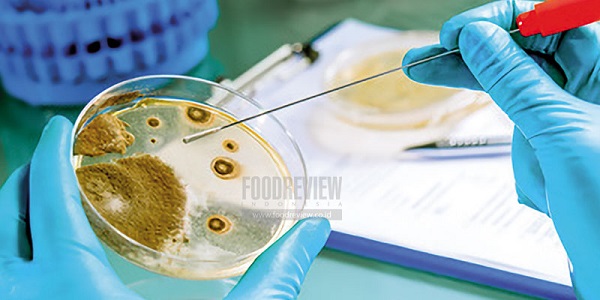

Standar Keamanan Produksi Prasyarat IKM Perluas Akses Pasar
:
0
Kementerian Perindustrian terus mendorong sektor industri pangan, termasuk yang berskala industri kecil dan menengah (IKM), agar memenuhi standar keamanan pangan.
EmitenNews.com - Kementerian Perindustrian terus mendorong sektor industri pangan, termasuk yang berskala industri kecil dan menengah (IKM), agar memenuhi standar keamanan pangan. Sebab, penerapan pedoman produksi olahan yang baik di setiap tahap produksi menjadi prasyarat untuk memperluas akses pasar, melindungi konsumen dan menjaga keberlanjutan usaha. Upaya ini juga meningkatkan kepercayaan pasar terhadap produk pangan dalam negeri di tengah ketatnya persaingan global.
“Dengan menerapkan standardisasi, produk IKM pangan akan semakin terjaga kualitasnya dan mendapat kepercayaan lebih besar dari konsumen, yang juga ikut mendukung perkembangan usaha mereka,” kata Menteri Perindustrian Agus Gumiwang Kartasasmita dalam keterangannya, Sabtu (6/9).
Direktur Jenderal Industri Kecil, Menengah dan Aneka (IKMA) Reni Yanita menjelaskan, jika merujuk pada fungsi dasarnya, pangan adalah kebutuhan dasar manusia yang berperan penting dalam menjaga kesehatan. Dengan demikian, keamanan pangan menjadi hal yang mutlak dalam proses produksinya agar kesehatan konsumen tetap terjamin.
“Berdasarkan Peraturan Pemerintah Nomor 86 Tahun 2019 tentang Keamanan, Mutu, dan Gizi Pangan, disebutkan bahwa setiap pihak yang bertanggung jawab dalam rantai pangan termasuk dalam proses produksi, penyimpanan, pengangkutan, dan peredaran pangan wajib memenuhi persyaratan sanitasi yang sesuai dengan ketentuan peraturan yang berlaku,” tuturnya.
Oleh karena itu, Ditjen IKMA Kemenperin terus memacu IKM pangan untuk memenuhi standar Good Manufacturing Practices (GMP) atau Cara Produksi Olahan yang Baik (CPPOB) dan Hazard Analysis and Critical Control Points (HACCP) atau sistem manajemen keamanan pangan yang dirancang. Tujuannya untuk mengidentifikasi, mencegah, mengevaluasi, dan mengendalikan bahaya yang bisa memengaruhi keamanan produk pangan.
“GMP dan HACCP adalah pedoman yang mengatur bagaimana perusahaan atau produsen memproduksi pangan secara aman, bermutu, dan layak konsumsi,” ujar Reni.
Guna meningkatkan daya saing dan kepercayaan pasar terhadap produk pangan nasional melalui kepatuhan penerapan standar HACCP, Ditjen IKMA menyelenggarakan Pendampingan Penyusunan Dokumen HACCP secara intensif bagi 10 IKM pangan terpilih yang terbagi dalam dua batch.
Pada batch pertama diikutii oleh APB Sambal, PT. Rahasia Kuliner Surga, CV. Kreasi Pangan Global, PT. Crispy Salad Moonbite, dan PT. Imago Randau Harmoni yang telah berlangsung pada Juni lalu. Sementara pendampingan batch kedua yang berlangsung pada 19–21 Agustus 2025, diikuti oleh CV. Kims Pangan Jaya, Novio Fresh, PT. Battenberg Tiga Indonesia, PT. Inovasi Pangan Global, dan PT. Kawani Jadi Berkat.(*)
Related News

Tokenisasi Aset Global Meledak, PINTU Perkuat Ekosistem 48 Opsi Aset

5 Saham Paling Boncos dan Tahan Gempuran di Sesi I IHSG (18/5)

KISI Terus Dorong Literasi dan Akses Investasi bagi Generasi Muda

Luluh-Lantak Nyaris 5 Persen! IHSG Dibombardir Sentimen Buruk Beruntun

Breaking: IHSG Awal Pekan Dibuka Jeblok 2 Persen Lebih ke Level 6.500

Wall Street Terjungkal, IHSG Ikut Tertekan




















